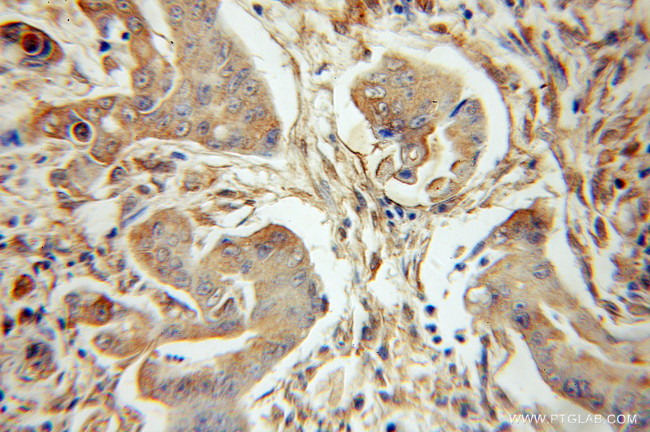
PLK3 Antibody in Immunohistochemistry (Paraffin) (IHC (P))

Search
Proteintech
PLK3 Polyclonal Antibody
{{$productOrderCtrl.translations['antibody.pdp.commerceCard.promotion.promotions']}}
{{$productOrderCtrl.translations['antibody.pdp.commerceCard.promotion.viewpromo']}}
{{$productOrderCtrl.translations['antibody.pdp.commerceCard.promotion.promocode']}}: {{promo.promoCode}} {{promo.promoTitle}} {{promo.promoDescription}}. {{$productOrderCtrl.translations['antibody.pdp.commerceCard.promotion.learnmore']}}
产品信息
10977-1-AP
种属反应
已发表种属
宿主/亚型
分类
类型
抗原
偶联物
形式
浓度
规格
纯化类型
保存液
内含物
保存条件
运输条件
产品详细信息
Immunogen sequence: SPRDRPSID QILRHDFFTK GYTPDRLPIS SCVTVPDLTP PNPARSLFAK VTKSLFGRKK KSKNHAQERD EVSGLVSGLM RTSVGHQDAR PEAPAASGPA PVSLVETAPE DSSPRGTLAS SGDGFEEGLT VATVVESALC ALRNCIAFMP PAEQNPAPLA QPEPLVWVSK WVDYSNKFGF GYQLSSRRVA VLFNNGTHMA LSANRKTVHY NPTSTKHFSF SVGAVPRALQ PQLGILRYFA SYMEQHLMKG GDLPSVEEVE VPAPPLLLQW VKTDQALLML FSDGTVQVNF YGDHTKLILS GWEPLLVTFV ARNRSACTYL ASHLRQLGCS PDLRQRLRYA LRLLRDRSPA (298-646 aa encoded by BC013899)
靶标信息
PLK3 is a member of the polo family of serine/threonine kinases. PLK3 is involved in the regulation of M phase in the cell cycle. CNK contains both a catalytic domain and a putative regulatory domain. It may play a role in regulation of cell cycle progression and tumorigenesis.
仅用于科研。不用于诊断过程。未经明确授权不得转售。
生物信息学
蛋白别名: cytokine inducible kinase; Cytokine-inducible serine/threonine-protein kinase; FGF-inducible kinase; PLK-3; Polo-like kinase 3; Proliferation-related kinase; serine-threonine kinase; Serine/threonine-protein kinase PLK3
基因别名: CNK; FNK; PLK-3; PLK3; PRK
UniProt ID: (Human) Q9H4B4, (Rat) Q9R011
Entrez Gene ID: (Human) 1263, (Rat) 58936, (Mouse) 12795